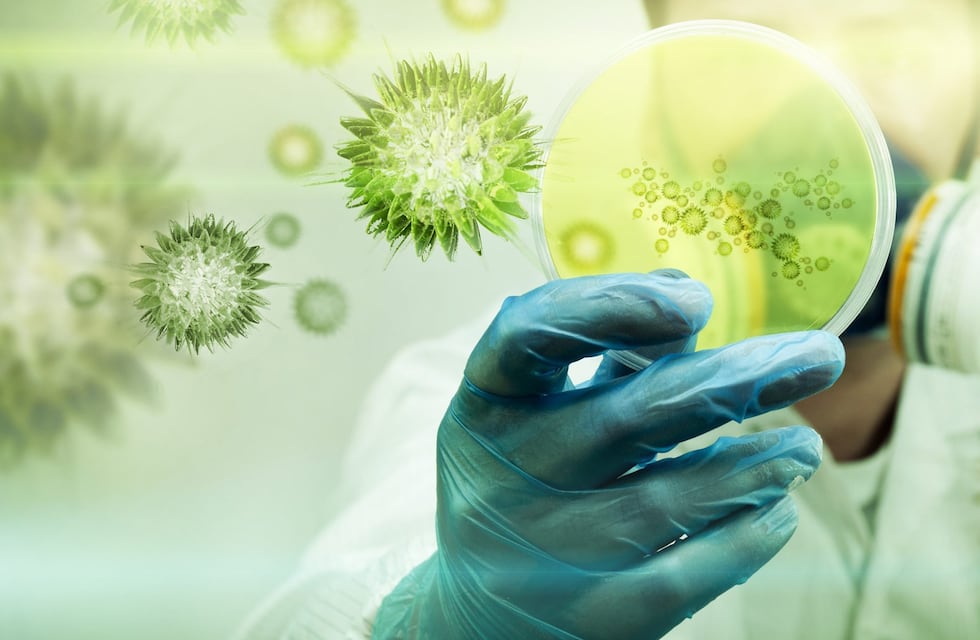

Durante la jornada de este domingo se analizaron 1811 muestras de las cuales se pudo contabilizar 86 casos positivos de coronavirus, según los datos aportados por el Comité de Crisis.
La distribución de los casos fue la siguiente: 39 pacientes son oriundos de San Luis, 9 de Villa Mercedes, 9 de La Punta, 6 de Arizona, 4 de Merlo, 3 de Justo Daract, 2 de Santa Rosa, 2 de San Francisco, 2 de La Toma, 2 de Juana Koslay, 2 de Anchorena, 1 de Candelaria, 1 de Quines, 1 de Potrero de los Funes, 1 de Villa del Carmen, 1 de Tilisarao y 1 de otra provincia.
Por el momento en la provincia de San Luis se contabilizan 19.254 casos, de los cuales 1385 están activos y 17.564 personas ya recibieron el alta. Afortunadamente, en la jornada no se notificaron fallecidos, por lo cual la cifra de víctimas fatales se mantiene en 305.
Cabe destacar que, 12 pacientes se encuentran con asistencia respiratoria mecánica ,en terapia intensiva.

Fuente: Gobierno de San Luis.